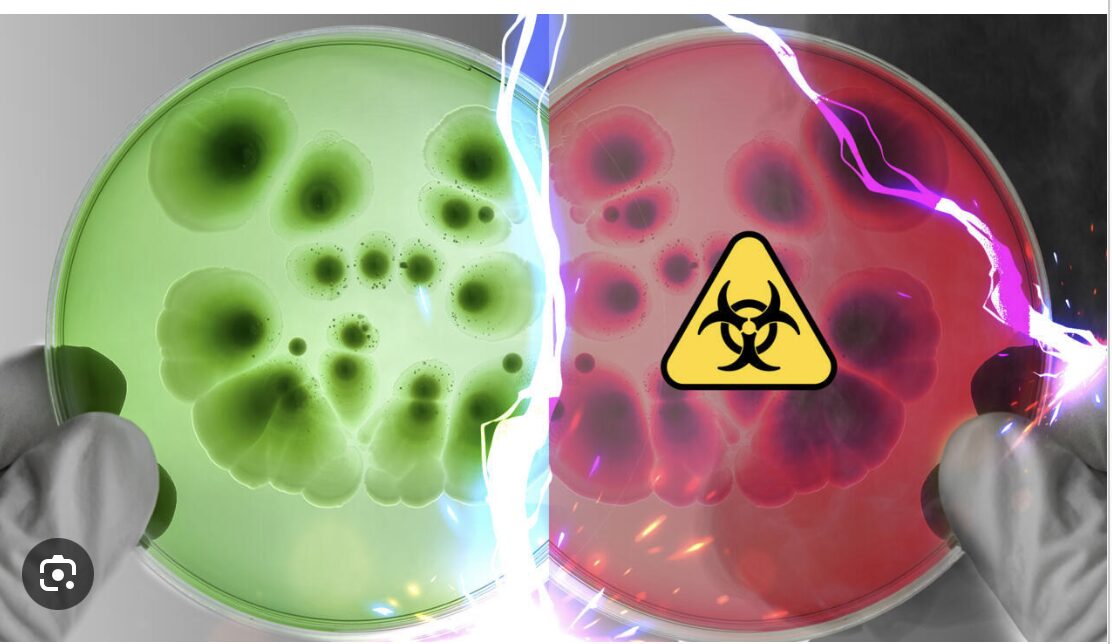

OUBLIEZ LE CLIMAT !
VOILÀ CE QUI POURRAIT VRAIMENT VOUS TUER.
Connaissez-vous les bactéries-miroir ?
Je sais que nous sommes dans une époque anxiogène où il est devenu courant d’inquiéter les foules sur un ensemble de sujets farfelus ou à tout le moins hautement hypothétiques, voire carrément improbables.
Nous avons droit aux pandémies, à la guerre nucléaire avec la Russie, au réchauffement climatique, tous capables de faire disparaître l’Humanité, n’est-ce pas ?
Bref, nos gouvernants, complaisamment relayés par des médias avides de sensation, entretiennent un sentiment d’insécurité permanent permettant de passer sous le tapis les vrais sujets.
Ainsi, perte de souveraineté, invasion migratoire, insécurité, émergence de narco-états, dette abyssale et appauvrissements (pécuniaire, intellectuel et moral) sont-ils relégués fort opportunément au niveau des chiens écrasés.
Quand l’urgence devient de « Sauver la Planète », pourquoi diable vous inquiéter de la « pseudo-taxe » de 6 centimes sur les carburants au 1er janvier prochain et destinée à promouvoir encore plus de voitures électriques ?
Quand la guerre est aux portes de l’Europe, peut-on encore trouver le temps de s’émouvoir des 400.000 migrants supplémentaires depuis le 1er janvier ?
Toute personne dotée d’un peu de discernement et connaissant un minimum les théoriciens du « gouvernement par la peur » (Platon, Hobbes, Montesquieu, Tchakhotine, Goering, Mencken, Orwell, Chomsky, Macron… ) ne peut qu’être amusée par ce grand cirque (si elle est cynique), ou acculée au suicide (si elle est timorée).
Je m’en voudrais de rajouter de l’angoisse à l’angoisse, cependant il est une cause réelle pouvant amener la destruction totale de la vie sur terre que presque personne ne connaît.
Connaissez-vous les bactéries-miroir ?
Comme c’est fort peu probable, je vais devoir faire preuve d’abord d’un peu de pédagogie en essayant d’éviter l’écueil du pédantisme.
Ce n’est pas évident car le sujet touche à la chiralité, terme barbare qui éveille encore en moi des angoisses d’étudiant avant les examens... C’est Louis Pasteur qui avait découvert ce concept en 1848 sur des cristaux d’acide tartrique [1].
Commençons par l’ADN. Tout le monde connaît cette fameuse chaîne sur laquelle sont encodés tous nos gènes. L’ADN est d’abord transcrit en ARN messagers (ARNm) par une enzyme et, au terme d’un processus complexe, il permettra de fabriquer toutes les protéines de notre corps (enzymes, protéines cellulaires, hormones.). L’ADN est aussi à l’origine de la production de tous nos anticorps au terme d’un processus encore plus complexe.
Or il se trouve que TOUTES les molécules d’ADN, quels que soient les êtres vivants, sont enroulées en spirale dans le même sens dit dextrogyre, composées de nucléotides « droitiers ».
C’est un peu comme un tire-bouchon : l’hélice tourne toujours dans le sens des aiguilles d’une montre.
Inversement, les protéines fabriquées sont systématiquement construites à partir d’acides aminés « gauchers ».
Simplifions pour que tout soit aisément compréhensible : l’ADN fabrique des millions de produits qui sont comme des gants exclusivement réservés aux gauchers.
Et c’est là qu’intervient la notion de chiralité. Il est possible pour les chercheurs de créer artificiellement les mêmes gants, mais réservés aux droitiers.
Le produit est dit alors « miroir ». Il a exactement la même composition que le produit « naturel », mais est en fait sa réplique vue dans un miroir.
Cette possibilité ouvre des perspectives infinies au niveau des traitements thérapeutiques.
Fabriquer la molécule « miroir » d’un médicament existant permet souvent d’en prolonger la durée de vie car il n’est pas dégradable par nos enzymes. En effet, celles-ci ne les « reconnaissent » pas. Elles ne peuvent que dégrader les produits naturels « gauchers ».
Vous ne le savez sûrement pas, mais ces médicaments existent déjà [2].
Ça marche donc et ces perspectives sont donc extrêmement prometteuses en médecine.
Jusque-là, tout va bien, me direz-vous.
Certes ! Mais accrochez vos ceintures, car les choses vont se compliquer :
Comme il est coûteux de fabriquer ces molécules thérapeutiques « miroir », des scientifiques ont eu une idée folle :
« Pourquoi ne pas créer des « bactéries-miroir », avec un ADN à pas inversé qui tout naturellement fabriqueront directement les substances recherchées à un coût dérisoire ».
Cette question s’avère fascinante car, au-delà de l’aspect de la sacro-sainte rentabilité, elle soulève des questions fondamentales.
Notamment pourquoi la Vie (ou Dieu, ou la Nature suivant vos convictions) a-t-elle opté pour un ADN dextrogyre, et non l’inverse ?
Quel fascinant défi de s’amuser à faire exactement le contraire pour voir comment ça marche !
Où en est-on techniquement ?
En 2022, des chercheurs chinois ont réussi à produire des ARN-miroirs après avoir synthétisé chimiquement une enzyme-miroir : une « ARN polymérase » capable d’agréger des nucléotides, les briques des ARN.
C’est une véritable prouesse, premier pas vers la bactérie-miroir.
Mais, comme je vous l’avais dit, le processus est excessivement complexe et remonter jusqu’à l’ADN inversé puis à une bactérie opérationnelle demanderait encore des recherches extraordinairement sophistiquées.
Pour y parvenir, il faudrait encore au moins dix années de recherche selon Ariel Lindner, directeur de l’unité Évolution et ingénierie de systèmes dynamiques (Inserm/Sorbonne Université), spécialiste en biologie de synthèse.
Supposons cependant que les recherches soient menées à terme. Un scénario d’apocalypse s’annonce alors :
Une fois créées, ces bactéries-miroir échapperaient à tous nos moyens de contrôle naturels.
Le monde du vivant actuel ne dispose absolument pas des outils pour lutter contre ces « objets » miroirs, que ce soit pour les détruire ou les dégrader.
Notre système immunitaire, nos antibiotiques, même les prédateurs naturels des bactéries comme certains virus ne pourraient rien contre elles. En effet, tous ces mécanismes naturels ne reposent uniquement que sur la reconnaissance de formes moléculaires « gauchères ».
Ainsi, invulnérables aux antibiotiques, insensibles à notre système immunitaire car non détectées par celui-ci, ces bactéries-miroir pourraient se reproduire à l’infini. Elles compromettraient l’existence du vivant sur toute la planète, bien au-delà de l’Homo sapiens.
.
Les chercheurs sont conscients de la gravité extrême de la situation.
En décembre 2024, 38 scientifiques de renommée mondiale se sont regroupés. Issus de neuf pays différents, ils ont publié un rapport de 300 pages dans la prestigieuse revue Science[3].
Parmi eux, on trouve plusieurs prix Nobel et des experts en immunologie, en écologie et en biosécurité (dont Yasmine Belkaid, directrice de l’Institut Pasteur[4]).
Unanimement, ils tirent la sonnette d’alarme : il faut déclarer un moratoire sur la recherche de création de bactéries-miroir.
Ceci est d’autant plus louable que les scientifiques pionniers de ces recherches sont les premiers signataires de ce moratoire (notamment Kate Adamala, professeur à l’université du Minnesota). C’est à ma connaissance un cas unique où un chercheur décide volontairement de mettre un terme à ses travaux.
Très récemment, en 2025, plusieurs conférences internationales se sont tenues : à l’Institut Pasteur, puis à Manchester et Singapour.
L’objectif était d’établir une ligne éthique et des réglementations claires avant qu’il ne soit trop tard.
Il y a eu unanimité. On est bien au-delà de « quasi-consensus » brandi autour du réchauffement climatique.
Il y a unanimité, oui. Mais…
Mais il est quasiment certain que la Chine poursuit ces recherches dans un cadre restreint et hautement sécurisé. Ting Zhu, biochimiste à l’Université de Westlake en Chine et pionnier dans ce domaine, n’a pas participé à l’appel de décembre 2024. Bien qu’il soutienne une approche prudente, il continue à plaider pour la poursuite des recherches sur les molécules miroir, estimant que les bénéfices potentiels justifient la prise de risques contrôlés. [5]
Or il existe un précédent inquiétant. En effet, en 2018, la convention d’Oviedo avait interdit les manipulations génétiques sur les cellules germinales humaines.
Malgré cela, des jumelles génétiquement modifiées sont nées en Chine, ce qui prouve le manque de crédibilité des autorités chinoises en la matière. Le chercheur incriminé a été momentanément emprisonné en Chine, mais aussitôt libéré, il a repris ses recherches[6]…
Faut-il aussi rappeler l’épisode du laboratoire de Wuhan ? La transparence n’est pas la principale vertu du Parti Communiste Chinois…
Qu’en conclure ?
Personnellement, je suis un fervent partisan du progrès, un fils naturel de Jules Verne.
Je reste persuadé que l’Humanité ne progressera que par la Science, malgré le néo-obscurantisme des écologistes.
Je suis par exemple un fervent partisan du nucléaire, un inconditionnel des OGM, consterné par les contre-vérités proférées sur le sujet.
Je suis admiratif du courage de Kenneth Bainbridge qui a osé « appuyer sur le bouton » pour déclencher pour la première fois le feu nucléaire en 1945 alors qu’Enrico Fermi avait pris des paris macabres sur le fait que l’explosion pouvait dévaster bien plus que la zone d’essai[7].
Je ne suis donc guère suspect d’être « anti-science » et confesse même volontiers être un zélote de la Science.
Cependant, je suis totalement opposé aux recherches permettant d’aboutir à la création sur Terre d’une bactérie-miroir. Potentiellement, c’est la fin de toute vie sur notre planète.
Alors, qui que vous soyez, vous pouvez mener les combats qui vous tiennent à cœur :
Faire payer les riches jusqu’à les saigner, taxer le carbone, militer pour des toilettes transgenres, prohiber le chauffage au bois, pénaliser les propriétaires de grosses voitures, entasser tous les habitants dans des HLM pour éviter d’artificialiser les sols, obliger toutes les filles à porter le hijab pour éviter de stigmatiser les minorités musulmanes, interdire la consommation de foie gras, obliger à manger végan dans les cantines, imposer un quota d’handicapés mentaux chez les élus pour faire cesser cette abominable discrimination d’une minorité, interdire les corridas, la chasse à la palombe, enseigner la théorie des genres à la maternelle etc.
Allez-y, délirez autant que vous voulez !
Lâchez-vous ! Si ça vous permet au moins de donner un sens à votre existence, pourquoi pas ?
Vos pires sottises ne m’effraient pas
Car elles sont réversibles. Une marche arrière est toujours possible et le bon sens a toutes les chances de vaincre un jour.
Mais si un jour vous avez un avis à émettre sur les bactéries-miroir, gardez présent à l’esprit ce que je vous affirme solennellement :
IL FAUT TOUT METTRE EN ŒUVRE POUR FAIRE CESSER CETTE FOLIE DE RECHERCHE SUR LES BACTÉRIES-MIROIR.
Vos autres combats n’auraient plus aucun sens car ils n’auraient plus aucune raison d’être, l’Humanité ayant disparu.
Tout simplement.
.
[1] Louis Pasteur, au milieu du XIXe siècle, a découvert cette propriété des molécules, appelée « chiralité », du grec« kheir » signifiant « main ». Il a observé que des cristaux d’acide tartrique, résidu de la fermentation du vin, faisaient tourner la polarisation de la lumière dans le sens des aiguilles d’une montre ou à l’inverse, en fonction de leur configuration tridimensionnelle.
[2] Degarelix et Difelikefalin pour les patients dialysés. Traitement en cours d’évaluation d’un peptide miroir pour bloquer le VIH.
[3] Adamala K.P. et al., « Confronting risks of mirror life », Science, décembre 2024
[4] Voir pétition Les Lignes Bougent
[5] Zhu, T. « Mirror of the unknown: should research on mirror-image molecular biology be stopped? » Nature, vol. 645, pp. 588-591 (2025)
[6] Sorti de prison en avril 2022, le chercheur He Jiankui a immédiatement repris ses travaux. Il dirige désormais un laboratoire à Pékin et a annoncé en 2025 la création d’un centre de recherche au Texas, affirmant que ses futures expériences respecteront cette fois les normes éthiques…
[7] Enrico Fermi proposa de prendre des paris parmi les principaux physiciens et militaires présents sur la question de savoir si l’atmosphère s’embraserait, et si oui, si cela détruirait seulement l’État du Nouveau-Mexique ou incinérerait la planète entière. (Wikipédia)
Raoul Girodet
1,067 total views, 1 views today

Vous nous alertez pour conclure en disant que vous êtes pro-OGM et pour le feu nucléaire, faisant fi de milliers d’individus qui ont été transformés en torche vivante, mutilés et pour les survivants rendus malades à vie, en réalité une longue agonie. Puisque vous êtes sans pitié je vous souhaite d’être confronté vous-même un jour aux conséquences d’un savant fou.
😊 Bonjour Raoul Girodet. Merci ce fut très intéressant. Et pour ma part je ne trouve pas que ce que venez de partager avec nous soit anxiogène. Au contraire je trouve votre démarche emplie de bon sens, de justesse et de lucidité. –> Qu’elle me semble bien loin l’époque où tous fiers, « ils » avaient annoncé à la face du monde, le clonage de la petite brebis Dolly. Je me souviens encore comment tous mes sens alors s’étaient mis en alerte (avec à l’intérieur une sorte de douleur indicible) et comment j’essayais de sonder les réactions des uns et des autres afin de vérifier si je ne dramatisais pas. Moi aussi je suis à 100% pour la Science et ses avancées, mais certainement pas pour les expériences de Savant fou à but eugéniste. Quant à Dolly, une tellement belle réussite que la malheureuse bête a fini par devoir être euthanasiée.
La vie n’existe que parce qu’il y a des molécules L et des molécules D. Ca peut sembler curieux mais c’est ainsi. L’exemple es 2 mains est bon, elles sont pareilles mais pas superposables. En chimie le meilleur exemple est l’acide ascorbique. La forme D n’a aucune qualité vitaminique, c’est un banal acide organique tout juste anti oxygène. Seule le forme L est une vitamine bien connue et indispensable : la vitamine C.
Bonjour Hagdik ne voulez-vous pas développer un peu cela dans un article pour l’édification des masses ? contact@resistancerepublicaine.com
Bonjour Mme Tasin,
C’est d’accord, je m’y mets. Donnez moi quelques jours.
parfait quand vous pouvez et voulez, merci
En fait c’est presque terminé, je pense vous l’envoyer ce week-end.
Cordialement
Je suis impatiente je vous écris depuis ma messagerie perso
Ces créateurs de bactéries -miroir peuvent-ils se regarder encore dans la glace ? À mon humble avis, il faut éliminer les chercheurs dès la naissance. Un test suffit, si le nourrisson est trop curieux, vous pouvez être sûr que c’est un futur chercheur de virus mortels, ou de bombes à large spectre de destruction. Idem s’il se frotte le pouce sur l’index, c’est un futur Mozart de la finance. Nous en avons un spécimen en ce moment. Si le protocole d’élimination avait eu cours à cette époque, nous n’en serions pas là aujourd’hui. 😂😂😂😂😇😇😇😇
Bonjour, la première fois que Kenneth Bainbrige à appuyé sur le bouton aurait pu avoir des conséquences bien pire! Si vous trouvez que l’arme nucléaire est un progrès, pourquoi avoir peur des bactéries miroir? En cas de conflit, la terre disparaîtrait de l’univers, il suffit qu’un petit dictateur de ma connaissance pique une crise pour déclencher l’Armageddon. Pour les OGM, mon avis est que le danger n’est pas de manger des produits qui en contiennent, on mange du cochon sans devenir cochon sauf bien sur pour certaines égéries de LFI mais les causes ne sont pas les mêmes ! Le danger vient surtout que des plantes génétiquement modifiées deviennent beaucoup plus résistantes et envahissent le biotope en devenant la seule espèce anthropique prépondérante. Les chercheurs devraient se mettre une barrière en prenant pour principe qu’une machine ne peut se penser elle-même et ne pas s’aventurer sur les secrets de la vie qui nous sont cachés, tout ces risques pour la notoriété ou la richesse ne valent pas la peine, souvenons nous de Mary Shelley et de son Frankenstein. Bonne journée.
Merci le Chti pour ce commentaire qui pointe l’essentiel en effet
Manger du cochon sans devenir cochon? Je pense à un certain sénateur et je me demande si une transmutation génétique n’a pas eu lieu en ce qui le concerne. Je pense que c’est possible. Macron a dû manger du pâté de scorpion lors de ses voyages en Afrique.
Cher Argo, je ne vois pas à qui tu fais allusion…🤣🤣🤣
Bonjour,
Oui — l’annonce a bien eu lieu, et des jumelles ont été prétendument « génétiquement modifiées » en Chine. Mais ces affirmations ne sont pas scientifiquement validées de façon indépendante : l’absence de publication revue par des pairs, les doutes sur l’efficacité de la modification, et les risques de mutations non intentionnelles rendent l’affaire hautement controversée. On ne peut pas dire qu’il y ait de preuve solide et publique que ces modifications aient réellement fonctionné comme annoncé, ni qu’elles soient « sans danger ».
Oui Gamma, attention aux annonces scientifique … écrites au conditionnel.
Science sans conscience n’est que ruine de l’âme.
Joli et pertinent, merci Julie